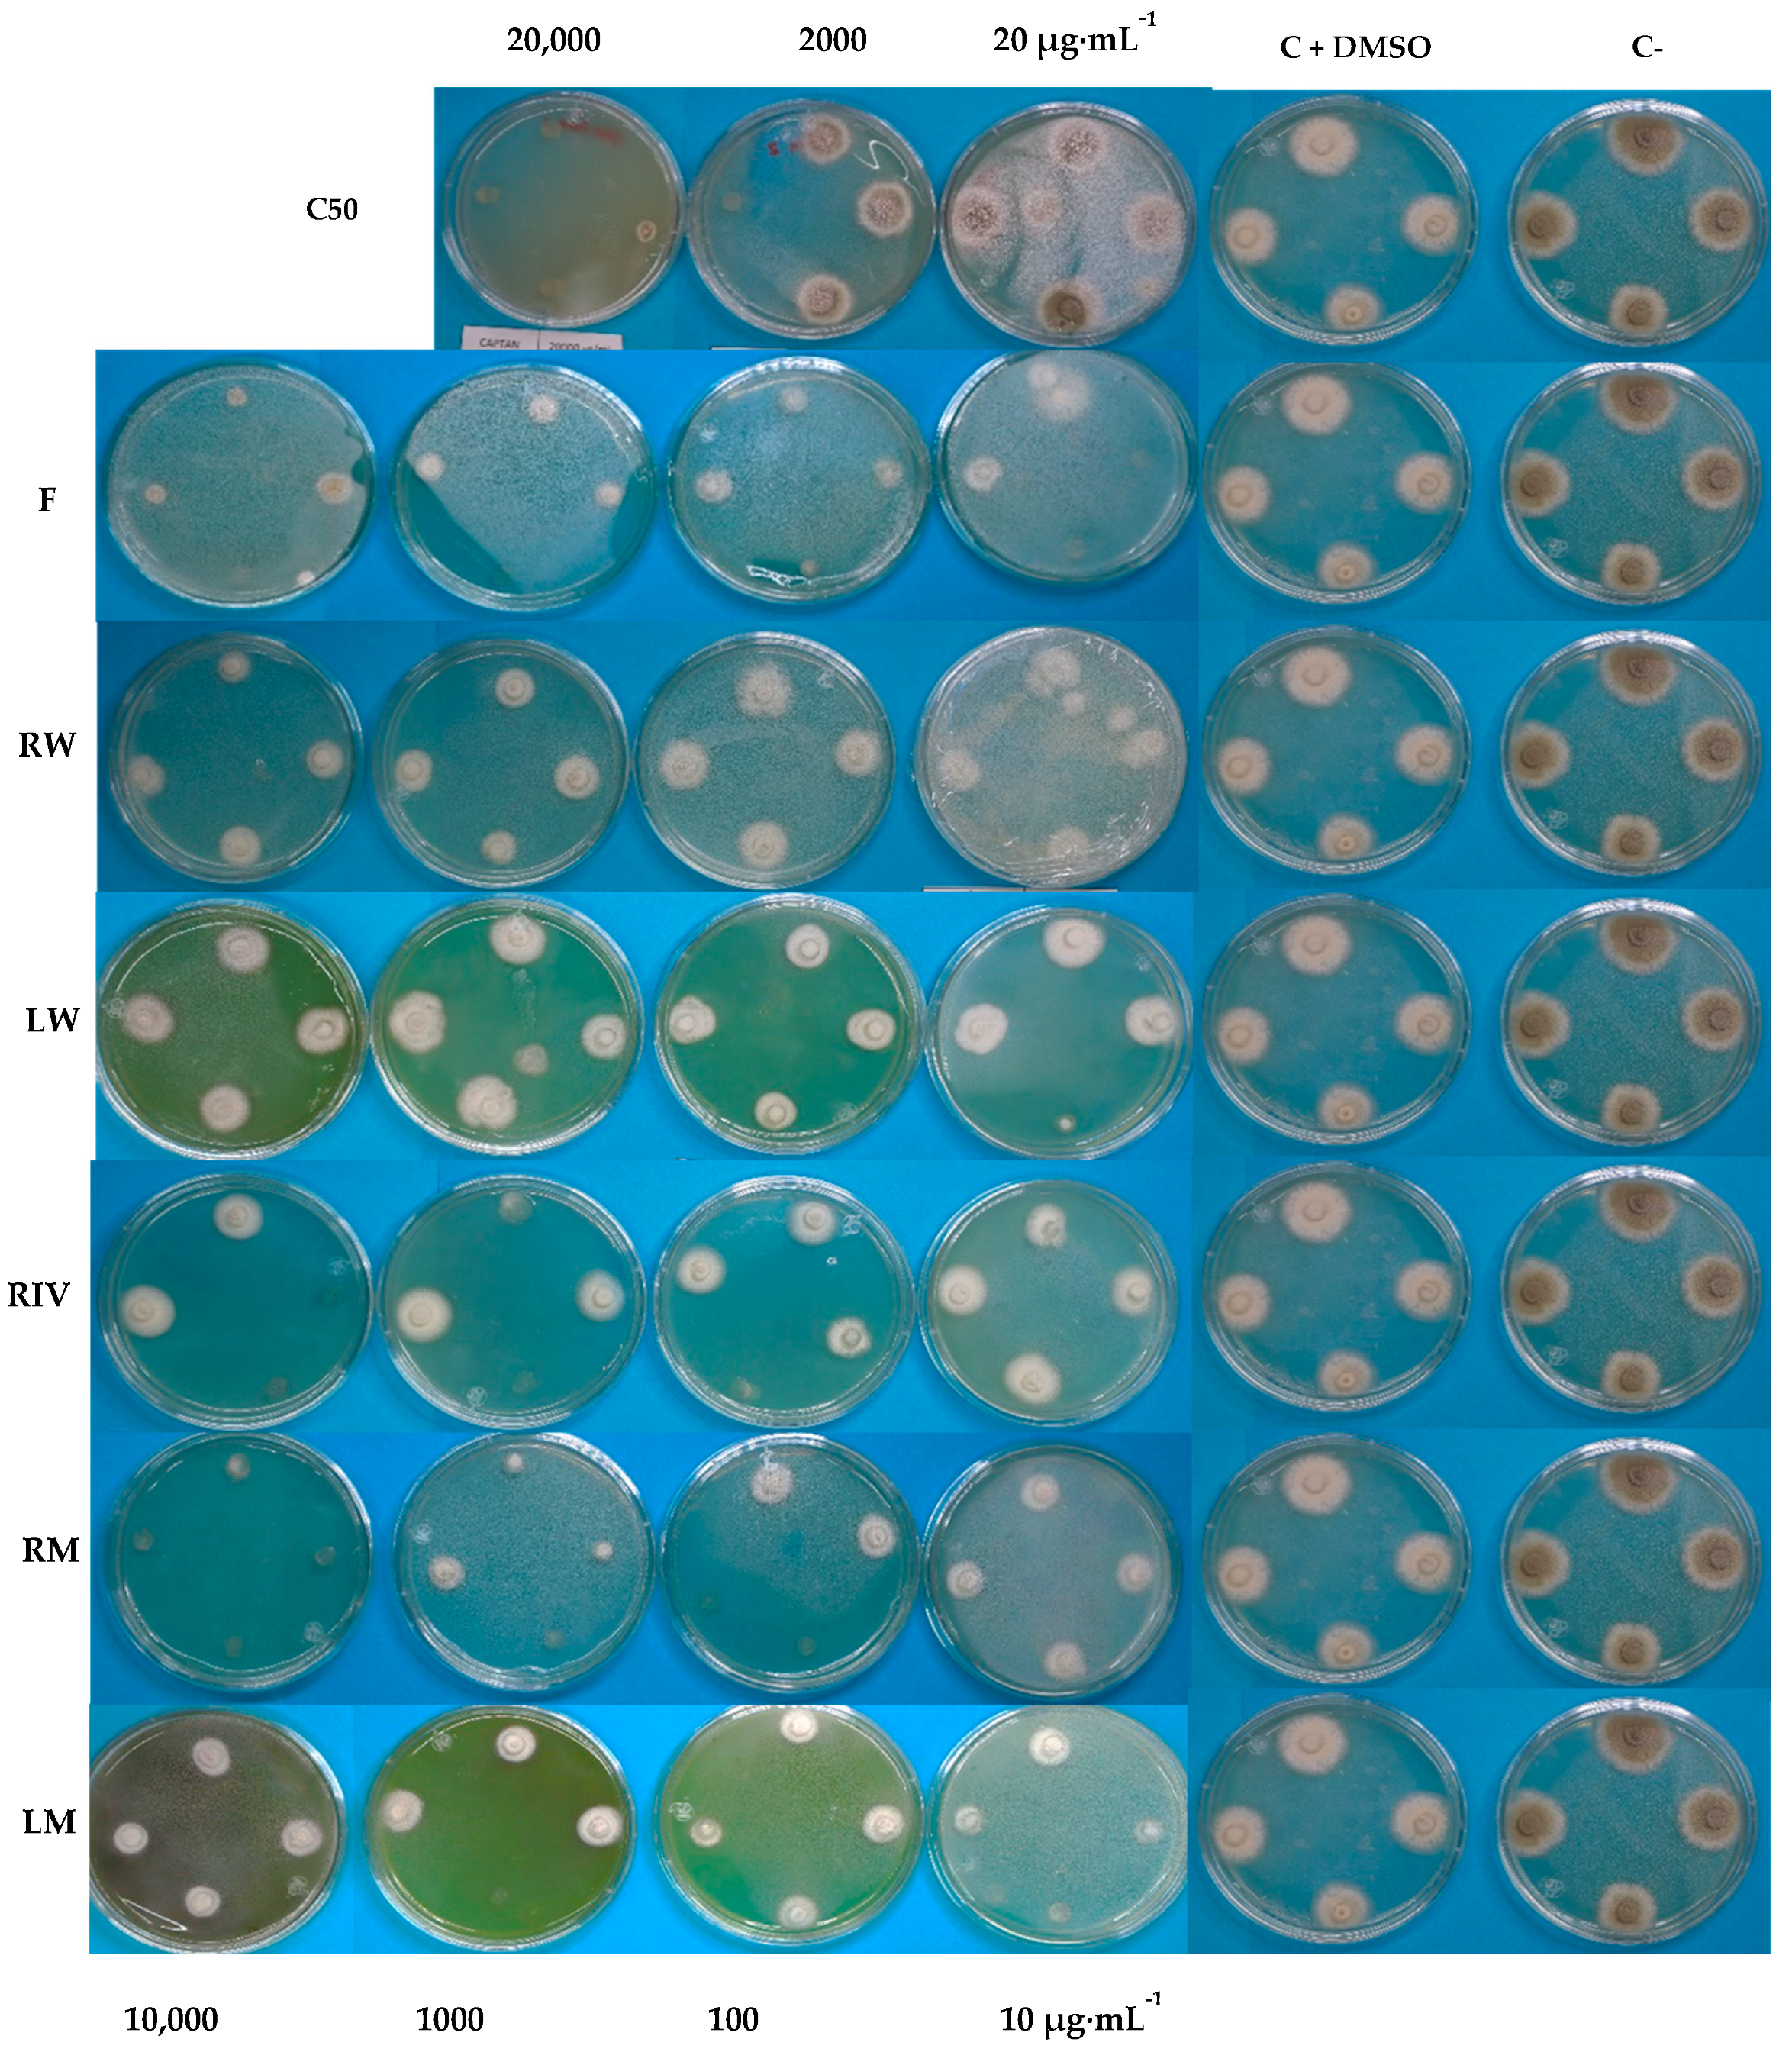
Plants 13 03586 g005

Antifungal Activity of Ethanolic Extracts from Aeroponically Grown Cape Gooseberry (Physalis peruviana L.) with LED Lights and In Vitro Habituated Roots
Abstract
1. Introduction
2. Results and Discussion
2.1. Antioxidant Activity
2.2. Total Polyphenol Content
2.3. Quantification of Quercetin and Apigenin on HPLC
2.4. Antifungal Activity of Extracts in Penicillium digitatum
2.5. Correlation of Antifungal Activity with Total Polyphenol Content
3. Materials and Methods
3.1. Media and Plant Culture
3.2. Establishment of the Aeroponic Culture
3.3. Establishment of Habituated In Vitro Root Culture
3.4. Processing of Plant Samples and Extraction
3.5. Determination Antioxidant Activity by DPPH
3.6. Determination of Total Polyphenols by Folin–Ciocâlteu Method
3.7. Determination of Antifungal Activity
3.8. Quantification of Quercetin and Apigenin on HPLC
3.9. Correlation of Total Polyphenol Content with Antioxidant/Antifungal Activity
3.10. Statistical Analysis
4. Discussion
5. Conclusions
Author Contributions
Funding
Data Availability Statement
Acknowledgments
Conflicts of Interest
References
- Ismail, M.; Zhang, J.Z. Post-harvest citrus diseases and their control. Outlooks Pest Manag. 2004, 15, 29–35. [Google Scholar] [CrossRef]
- Margosan, D.A.; Smilanick, J.L.; Simmons, G.F.; Henson, D.J. Combination of hot water and ethanol to control postharvest decay of peaches and nectarines. Plant Dis. 1997, 81, 1405–1409. [Google Scholar] [CrossRef] [PubMed]
- Amiri, A.; Bompeix, G. Diversity and population dynamics of Penicillium spp. on apples in pre- and postharvest environments: Consequences for decay development. Plant Pathol. 2005, 54, 74–81. [Google Scholar] [CrossRef]
- Dennis, C. Postharvest Pathology of Fruits and Vegetables; Academic Press: London, UK, 1983; 264p. [Google Scholar]
- Sanderson, P.G.; Spotts, R.A. Postharvest decay of winter pear and apple fruit caused by species of Penicillium. Phytopathology 1995, 85, 103–110. [Google Scholar] [CrossRef]
- Plaza, P.; Usall, J.; Torres, R.; Lamarca, N.; Vinas, I. Control of green and blue mold by curing on orange during ambient and cold storage. Postharvest Biol. Technol. 2003, 28, 195–198. [Google Scholar] [CrossRef]
- Cocco, M.; Vázquez, D.E.; Albors, A.; Cháfer, M.; Meier, G.E.; Bello, F. Combinación de tratamientos térmicos y bicarbonato de sodio para el control de Penicillium digitatum en frutos cítricos. Rev. Iberoam. Tecnol. Postcosecha 2008, 9, 55–62. [Google Scholar]
- Wilson, C.L.; Ghaouth, A.E.; Wisniewski, M.E. Prospecting in nature’s storehouse for biopesticides. Rev. Mex. Fitopatol. 1999, 17, 49–53. [Google Scholar]
- Montes, B.R.; Figueroa, B.R. Biocontrol de hongos en granos almacenados. In Plantas: Biotecnología, Agronomía, Nutrición; Bermúdez, T.K., Jiménez, P., Eds.; COFAA-IPN: Ciudad de México, Mexico, 1995; pp. 26–30, 66. [Google Scholar]
- García, A.Á.; Carril, E.P.U. Metabolismo secundario de plantas. Reduca (Biol.) 2011, 2, 119–145. [Google Scholar]
- Cowan, M.M. Plant products as antimicrobial agents. Clin. Microbiol. Rev. 1999, 12, 564–582. [Google Scholar] [CrossRef] [PubMed] [PubMed Central]
- Gómez-Caravaca, A.M.; Verardo, V.; Berardinelli, A.; Marconi, O.; Caboni, M.F. Physalis peruviana: Una fuente natural de compuestos bioactivos con efectos antifúngicos. Food Chem. 2013, 141, 1004–10101. [Google Scholar]
- Goyeneche, R.; Díaz, D.A.; Aguilera, J.M.; Tapia, M.S. Efecto de la temperatura y la actividad de agua sobre el crecimiento y la producción de micotoxinas de Aspergillus niger y Penicillium expansum en uchuva (Physalis peruviana L.). Food Sci. Technol. Int. 2014, 20, 55–652. [Google Scholar]
- Puente, L.A.; Pinto-Muñoz, C.A.; Castro, E.S.; Cortés, M. Physalis peruviana Linnaeus, the multiple properties of a highly functional fruit: A review. Food Res. Int. 2011, 44, 1733–1740. [Google Scholar] [CrossRef]
- Verma, N.; Shukla, S. Impact of various factors responsible for fluctuation in plant secondary metabolites. J. Appl. Res. Med. Aromat. Plants 2015, 2, 105–113. [Google Scholar] [CrossRef]
- Martínez-Zamora, L.; Castillejo, N.; Gómez, P.A.; Artés-Hernández, F. Efecto de mejora de la iluminación LED en la síntesis de compuestos bioactivos durante el brote de zanahoria. Agronomía 2021, 11, 304. [Google Scholar] [CrossRef]
- Qian, H.; Liu, T.; Deng, M.; Miao, H.; Cai, C.; Shen, W.; Wang, Q. Effects of light quality on main health-promoting compounds and antioxidant capacity of Chinese kale sprouts. Food Chem. 2016, 196, 1232–1238. [Google Scholar] [CrossRef]
- Huang, J.; Xu, Y.; Duan, F.; Du, X.; Yang, Q.; Zheng, Y. Improvement of the Growth and Nutritional Quality of Two-leaf-color Pak Choi by Supplemental Alternating Red and Blue Light. HortScience 2020, 1, 118–125. [Google Scholar] [CrossRef]
- Trivellini, A.; Toscano, S.; Romano, D.; Ferrante, A. The Role of Blue and Red Light in the Orchestration of Secondary Metabolites, Nutrient Transport and Plant Quality. Plants 2023, 12, 2026. [Google Scholar] [CrossRef]
- Lim, Y.J.; Kwon, S.J.; Eom, S.H. Red and blue light-specific metabolic changes in soybean seedlings. Front. Plant Sci. 2023, 14, 1128001. [Google Scholar] [CrossRef]
- Castillo, A. Propagación de Plantas por Cultivo In Vitro: Una Biotecnología que nos Acompaña Hace Mucho Tiempo. 2023. Available online: https://phys.org/news/2023-07-korean-team-room-temperature-ambient-pressure-superconductor.html (accessed on 7 October 2024).
- Rajewski, A.C.; Elkins, K.B.; Henry, A.; Eck, J.V.; Litt, A. In vitro plant regeneration and Agrobacterium tumefaciens mediated transformation of Datura stramonium (Solanaceae). Appl. Plant Sci. 2019, 7, 1–5. [Google Scholar] [CrossRef]
- Meins, F., Jr. Habituation: Heritable variation in the requirement of cultured plant cells for hormones. Annu. Rev. Genet. 1989, 23, 395–408. [Google Scholar] [CrossRef]
- Tabart, J.; Kevers, C.; Evers, D.; Dommes, J. Ascorbic Acid, Phenolic Acid, Flavonoid, and Carotenoid Profiles of Selected Extracts from Ribes nigrum. J. Agric. Food Chem. 2011, 59, 4763–4770. [Google Scholar] [CrossRef] [PubMed]
- Arnous, A.; Makris, D.P.; Kefalas, P. Correlation of Pigment and Flavanol Content with Antioxidant Properties in Selected Aged Regional Wines from Greece. J. Food Compos. Anal. 2002, 15, 655–665. [Google Scholar] [CrossRef]
- Ochoa Fuentes, Y.M.; Cerna Chávez, E.; Landeros Flores, J.; Hernández Camacho, S.; Delgado Ortiz, J. Evaluación in vitro de la actividad antifúngica de cuatro extractos vegetales metanólicos para el control de tres especies de Fusarium spp. Phyton 2012, 81, 69–73. [Google Scholar]
- Hernández, R.; Fernández, C.; Baptista, P. Metodología de la Investigación, 6th ed.; McGraw-Hill: New York City, NY, USA, 2014; pp. 304–306. [Google Scholar]
- Govindappa, M.; Bharath, N.; Shruthi, H.B.; Sadananda, T.S.; Sharanappa, P. Antimicrobial, antioxidant and in vitro anti-inflammatory activity and phytochemical screening of Crotalaria pallida Aiton. Afr. J. Pharm. Pharmacol. 2011, 5, 2359–2371. [Google Scholar] [CrossRef]
- García Cerrillo, A.; Hernández Hernández, J.; Martínez Ayala, A. Síntesis de antioxidantes y modificaciones morfológicas en función de la luz en lechuga. Rev. Jóvenes Cienc. 2018, 4, 1–6. [Google Scholar]
- Narváez-Cuenca, C.E.; Mateus-Gómez, Á.; Restrepo-Sánchez, L.P. Antioxidant capacity and total phenolic content of air-dried cape gooseberry (Physalis peruviana L.) at different ripeness stages. Agron. Colomb. 2014, 32, 232–237. [Google Scholar] [CrossRef]
- Ertürk, Ö.; Çol Ayvaz, M.; Can, Z.; Karaman, Ü.; Korkmaz, K. Antioxidant, Antimicrobial Activities and Phenolic and Chemical Contents of Physalis peruviana L. from Trabzon, Turkey. Indian J. Pharm. Educ. Res. 2017, 51, S213–S216. [Google Scholar] [CrossRef]
- Chiang, H.; Díaz, S.; Acevedo, C.; Cassels, B.K. Contenido de polifenoles y actividad antioxidante de varias especies vegetales de la zona centro-sur de Chile. Arch. Latinoam. Nutr. 1992, 42, 255–263. [Google Scholar]
- Shimizu, M.; Saito, T.; Goto, E.; Kondo, T. Effect of light quality on growth and vegetable quality in leaf lettuce, spinach and komatsuna. Environ. Control Biol. 2016, 54, 27–32. [Google Scholar]
- El-Beltagi, H.S.; Mohamed, H.I.; Safwat, G.; Gamal, M.; Megahed, B.M. Chemical Composition and Biological Activity of Physalis peruviana L. Bioactive Compounds in Phytomedicine. Gesunde Pflanz. 2019, 71, 113–122. [Google Scholar] [CrossRef]
- Liu, Y.; Fang, S.; Yang, W.; Shang, X.; Fu, X. Light quality affects flavonoid production and related gene expression in Cyclocarya paliurus. J. Photochem. Photobiol. B Biol. 2018, 179, 66–73. [Google Scholar] [CrossRef]
- Yousefbeyk, F.; Gohari, A.R.; Hashemighahderijani, Z.; Ostad, S.N.; Sourmaghi, M.H.S.; Amini, M.; Golfakhrabadi, F.; Jamalifar, H.; Amin, G.; Amin, M. Erratum to: Bioactive terpenoids and flavonoids from Daucus littoralis Smith subsp. hyrcanicus Rech.f, an endemic species of Iran. DARU J. Pharma. Sci. 2014, 22, 12. [Google Scholar] [CrossRef]
- Lee, H.; Woo, E.-R.; Lee, D.G. Apigenin induces cell shrinkage in Candida albicans by membrane perturbation. FEMS Yeast Res. 2018, 18, foy003. [Google Scholar] [CrossRef] [PubMed]
- Djouossi, M.G.; Tamokou, J.-d.-D.; Ngnokam, D.; Kuiate, J.-R.; Tapondjou, L.A.; Harakat, D.; Voutquenne-Nazabadioko, L. Antimicrobial and antioxidant flavonoids from the leaves of Oncoba spinosa Forssk. (Salicaceae). BMC Compl. Altern. Med. 2015, 15, 134. [Google Scholar] [CrossRef]
- Baptista, R.; Madureira, A.M.; Jorge, R.; Adão, R.; Duarte, A.; Duarte, N.; Lopes, M.M.; Teixeira, G. Antioxidant and Antimycotic Activities of Two Native Lavandula Species from Portugal. Evid. Based Compl. Altern. Med. 2015, 2015, 570521. [Google Scholar] [CrossRef]
- Thwe, A.A.; Kim, Y.B.; Li, X.; Seo, J.M.; Kim, S.J.; Suzuki, T.; Chung, S.O.; Park, S.U. Effects of light-emitting diodes on expression of phenylpropanoid biosynthetic genes and accumulation of phenylpropanoids in Fagopyrum tataricum sprouts. J. Agric. Food Chem. 2014, 62, 4839–4845. [Google Scholar] [CrossRef] [PubMed]
- Kim, Y.J.; Kim, Y.B.; Li, X.; Choi, S.R.; Park, S.; Park, J.S.; Lim, Y.P.; Park, S.U. Accumulation of phenylpropanoids by white, blue, and red light irradiation and their organ-specific distribution in Chinese cabbage (Brassica rapa ssp. pekinensis). J. Agric. Food Chem. 2015, 63, 6772–6778. [Google Scholar] [CrossRef] [PubMed]
- Gandarilla-Pacheco, F.L.; Torres-Caraballo, S.; de Luna-Santillana, E.J.; Quintero-Zapata, I.; Arroyo-González, N. Efecto inhibitorio de aceites esenciales en el crecimiento micelial de Penicillium digitatum (pers.) sacc. aislado de naranja dulce (citrus sinensis osbeck). Agrociencia 2020, 54, 209–225. [Google Scholar]
- Rai, N.; Kumari, S.; Singh, S.; Saha, P.; Pandey, A.K.; Pandey-Rai, S. Modulation of morpho-physiological attributes and in situ analysis of secondary metabolites using Raman spectroscopy in response to red and blue light exposure in Artemisia annua. Environ. Exp. Bot. 2023, 217, 105563. [Google Scholar] [CrossRef]
- Su, P.; Ding, S.; Wang, D.; Kan, W.; Yuan, M.; Chen, X.; Tang, C.; Hou, J.; Wu, L. Plant morphology, secondary metabolites and chlorophyll fluorescence of Artemisia argyi under different LED environments. Photosynth. Res. 2023, 217, 105563. [Google Scholar] [CrossRef]
- Paponov, M.; Ziegler, J.; Paponov, I.A. Light exposure of roots in aeroponics enhances the accumulation of phytochemicals in aboveground parts of the medicinal plants Artemisia annua and Hypericum perforatum. Front. Plant Sci. 2023, 14, 1079656. [Google Scholar] [CrossRef] [PubMed]
- González-Álvarez, M.; Moreno-Limón, S.; Salcedo-Martínez, S.M.; Pérez-Rodríguez, E.C. Evaluación in vitro de la actividad antifúngica de extractos de agave (Agave scabra Salm Dyck) sobre hongos postcosecha. Phyton 2015, 84, 427–434. [Google Scholar]
- Tran, H.M.; Le, D.H.; Nguyen, V.-A.T.; Vu, T.X.; Thanh, N.T.K.; Giang, D.H.; Dat, N.T.; Pham, H.T.; Muller, M.; Nguyen, H.Q. Penicillium digitatum as a Model Fungus for Detecting Antifungal Activity of Botanicals: An Evaluation on Vietnamese Medicinal Plant Extracts. J. Fungi 2022, 8, 956. [Google Scholar] [CrossRef]
- Shen, Y.; Chen, C.; Cai, N.; Yang, R.; Chen, J.; Kahramanoǧlu, I.; Okatan, V.; Rengasamy, K.R.R.; Wan, C. The Antifungal Activity of Loquat (Eriobotrya japonica Lindl.) Leaves Extract Against Penicillium digitatum. Front. Nutr. 2021, 8, 663584. [Google Scholar] [CrossRef]
- Pérez, C.; Rojas, A.; Chamorro, J.; Pérez, l.; Katy, P. Evaluación de la actividad antifúngica de Melia azederach L. sobre aislados de colletotrichum spp. Rev. Colomb. Cienc. Anim. 2011, 3, 309–320. [Google Scholar] [CrossRef]
- Ordoñez-Gómez, E.S.; Reátegui-Díaz, D.; Villanueva-Tiburcio, J.E. Polifenoles totales y capacidad antioxidante en cáscara y hojas de doce cítricos. Sci. Agropecu. 2018, 9, 113–121. [Google Scholar] [CrossRef]
- Mostafa, A.; Sudisha, J. Saponins Versus Plant Fungal Pathogens.Bioactive Molecules in Plant Defense; Springer: Cham, Switzerland, 2019; pp. 37–45. [Google Scholar] [CrossRef]
- Hernández, P.M.M. Actividad antioxidante y citotoxica de las fisalinas y de los flavonoides presentes en las hojas de Physalis peruviana L. Tesis de magíster en Recursos Vegetales y Terapéuticos. Master’s Thesis, Facultad de Farmacia y Bioquímica, Universidad Nacional Mayor de San Marcos, Lima, Perú, 2015; p. 85. [Google Scholar]
- Mayorga-Cubillos, F.; Arguelles, J.; Rodriguez, E.; Almario, C.; Ariza, C.; Barrero, L. Yield and physicochemical quality of Physalis peruviana L. fruit related to the resistance response against Fusarium oxysporum f. sp. physali. Agron. Colomb. 2019, 37, 120–128. [Google Scholar] [CrossRef]
- Alrifai, O.; Hao, X.; Marcone, M.F.; Tsao, R. Current Review of the Modulatory Effects of LED Lights on Photosynthesis of Secondary Metabolites and Future Perspectives of Microgreen Vegetables. J. Agric. Food Chem. 2019, 67, 6075–6090. [Google Scholar] [CrossRef]
- Al Murad, M.; Razi, K.; Jeong, B.; Samy, P.; Muneer, S. Light Emitting Diodes (LEDs) as Agricultural Lighting: Impact and Its Potential on Improving Physiology, Flowering, and Secondary Metabolites of Crops. Sustainability 2021, 13, 1985. [Google Scholar] [CrossRef]
- Coscedillã Oveanu, A.; Cabrera, R.; Mariño, C.G.; Iacomi, B.M.; González-Coloma, A. Antifungal activity of plant extracts against pre and postharvest pathogens. Agronomy 2013, LVI, 206–211. [Google Scholar]
- Simonetti, G.; Valletta, A.; Kolesova, O.; Pasqua, G. Plant Products with Antifungal Activity: From Field to Biotechnology Strategies. In Natural Products as Source of Molecules with Therapeutic Potential; Springer: Cham, Switzerland, 2017. [Google Scholar] [CrossRef]

| Extract | Quercetin | Apigenin |
|---|---|---|
| mM ∙ 1 g −1 DW | mM ∙ 1 g −1 DW | |
| RW | 0.0002307 A | 0.0003362 E |
| RM | 0 B | 0.3703847 A |
| RIV | 0.04768 A | 0.361266 B |
| LW | 0.009228 A | 0.00512 D |
| LM | 0 B | 0.00704 C |
| Treatment | IC50 (µg·mL−1) | Equation | Determination Coefficient |
|---|---|---|---|
| RW | 1702.15 | y = −2 × 10−6 x2 + 0.0198 x + 22.092 | R2 = 0.8495 |
| RM | 53.15 | y = −3 × 10−6 x2 + 0.0341 x + 48.106 | R2 = 0.9592 |
| F | 62.18 | y = −8 × 10−7 x2 + 0.0119 x + 50.743 | R2 = 0.9971 |
| C50 | 2297.32 | y = −5 × 10−7 x2 + 0.0146 x + 19.098 | R2 = 1 |
| RIV | 1169.55 | y = −3 × 10−6 x2 + 0.0319 x + 16.795 | R2 = 0.8394 |
| LW | 2715.86 | y = −1 × 10−6 x2 + 0.0167 x + 12.021 | R2 = 0.9997 |
| LM | 286.34 | y = 1 × 10−7 x2 + 0.0002 x + 55.249 | R2 = 0.9797 |
| Pearson Correlation | |||||
|---|---|---|---|---|---|
| Value 1 | Value 2 | N | Correlation r | IC 99% | p Value |
| Antifungal activity (%) | Total polyphenol content | 24 | −0.293 | (−0.698, 0.254) | 0.165 |
| Nutrient Solution (meq·L−1) | Concentration | NO3− | H2PO4− | SO42− | K+ | Ca2+ | Mg2+ |
|---|---|---|---|---|---|---|---|
| 15 | % | 0.75 | 0.15 | 0.1 | 0.34 | 0.42 | 0.24 |
| meq·L−1 | 11.25 | 2.25 | 1.5 | 5.1 | 6.3 | 3.6 |
| R | Interpretation |
|---|---|
| 0.90 | Very strong negative correlation |
| 0.75 | Considerable negative correlation |
| 0.50 | Medium negative correlation |
| 0.25 | Weak negative correlation |
| 0.10 | Very weak negative correlation |
| 0.00 | No correlation |
| 0.10 | Very weak positive correlation |
| 0.25 | Weak positive correlation |
| 0.50 | Medium positive correlation |
| 0.75 | Considerable positive correlation |
| 0.90 | Very strong positive correlation |
| 1.00 | Perfect positive correlation |
Disclaimer/Publisher’s Note: The statements, opinions and data contained in all publications are solely those of the individual author(s) and contributor(s) and not of MDPI and/or the editor(s). MDPI and/or the editor(s) disclaim responsibility for any injury to people or property resulting from any ideas, methods, instructions or products referred to in the content. |
© 2024 by the authors. Licensee MDPI, Basel, Switzerland. This article is an open access article distributed under the terms and conditions of the Creative Commons Attribution (CC BY) license (https://creativecommons.org/licenses/by/4.0/).
Share and Cite
Avila-Avila, D.E.; Rodríguez-Mendiola, M.A.; Arias-Castro, C.; Arias-Rodríguez, L.I.; Avila-Miranda, M.E.; Mancilla-Margalli, N.A. Antifungal Activity of Ethanolic Extracts from Aeroponically Grown Cape Gooseberry (Physalis peruviana L.) with LED Lights and In Vitro Habituated Roots. Plants 2024, 13, 3586. https://doi.org/10.3390/plants13243586
Avila-Avila DE, Rodríguez-Mendiola MA, Arias-Castro C, Arias-Rodríguez LI, Avila-Miranda ME, Mancilla-Margalli NA. Antifungal Activity of Ethanolic Extracts from Aeroponically Grown Cape Gooseberry (Physalis peruviana L.) with LED Lights and In Vitro Habituated Roots. Plants. 2024; 13(24):3586. https://doi.org/10.3390/plants13243586
Chicago/Turabian StyleAvila-Avila, Daniel Eduardo, Martha Alicia Rodríguez-Mendiola, Carlos Arias-Castro, Laura Isabel Arias-Rodríguez, Martin Eduardo Avila-Miranda, and Norma Alejandra Mancilla-Margalli. 2024. "Antifungal Activity of Ethanolic Extracts from Aeroponically Grown Cape Gooseberry (Physalis peruviana L.) with LED Lights and In Vitro Habituated Roots" Plants 13, no. 24: 3586. https://doi.org/10.3390/plants13243586
APA StyleAvila-Avila, D. E., Rodríguez-Mendiola, M. A., Arias-Castro, C., Arias-Rodríguez, L. I., Avila-Miranda, M. E., & Mancilla-Margalli, N. A. (2024). Antifungal Activity of Ethanolic Extracts from Aeroponically Grown Cape Gooseberry (Physalis peruviana L.) with LED Lights and In Vitro Habituated Roots. Plants, 13(24), 3586. https://doi.org/10.3390/plants13243586







